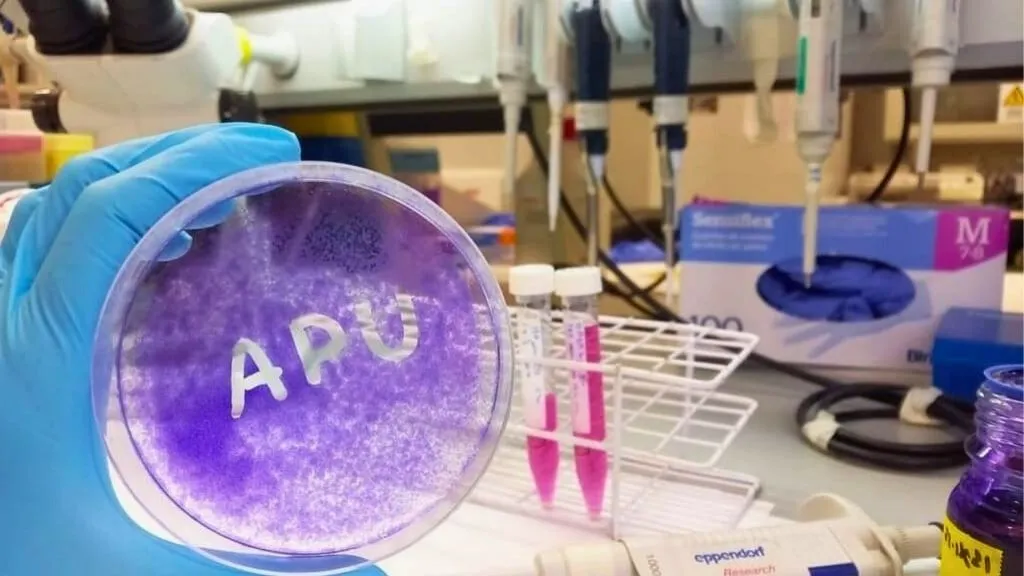

Desde hace años, la Asociación Pablo Ugarte se ha convertido en uno de los grandes financiadores de la investigación del cáncer infantil.
En pocos días, se cumplirán catorce años desde que el pequeño Pablo, Pablete para su familia y amigos, nos dejó víctima de un sarcoma de Ewing, un tipo de cáncer de tejidos blandos que afecta a niños y adultos jóvenes.
Ese 27 de noviembre del 2010 nadie podía pensar que unos años después y gracias al empuje de toda su familia, la asociación que lleva su nombre se convertiría en una de las principales fuentes de financiación de la investigación del cáncer infantil en España.
En la actualidad, la Asociación Pablo Ugarte destina más de 600.000 euros anuales a financiar una treintena de proyectos de 25 hospitales pediátricos repartidos por todo el territorio. Entre ellos, la Asociación da apoyo continuado al grupo de investigación del sarcoma de Ewing del Hospital Sant Joan de Déu Barcelona liderado por el doctor Jaume Mora, con el que mantiene un convenio desde el año 2011 que permite financiar parte del personal investigador, así como equipos y material del mismo. Sólo en este año 2024, la donación a este proyecto superará los 38.000 euros.
Recordemos que la baja incidencia del cáncer infantil respecto a los adultos – se diagnostica un caso de cáncer pediátrico por cada 200 en adultos- implica que tenga la consideración de enfermedad minoritaria. La falta de recursos públicos y privados para su investigación hace imprescindible la existencia de asociaciones de familias de pacientes como la de Pablo, que permiten seguir avanzando en el desarrollo de nuevas terapias.
Sin duda, este es el mejor legado que Pablo nos podía dejar. Gracias a la investigación, en el futuro, otros niños y niñas tendrán la oportunidad de beneficiarse de nuevos tratamientos que les ayuden a superar esta enfermedad.